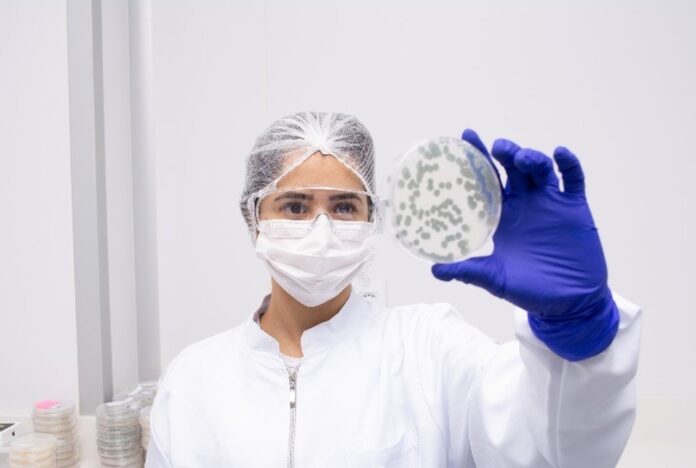

Os fungos do gênero Trichoderma (Hipocrales, Ascomycota) estão entre os microrganismos mais estudados do mundo como agentes de biocontrole de fitopatógenos e também como promotores de crescimento das plantas. Diante de todas as ações benéficas que o Trichoderma pode proporcionar para a agricultura, a SoluBio – empresa que atua na produção de bioinsumos nas fazendas – tem investido de forma significativa para criar insumos biológicos e formulações à base deste microrganismo que contribuam na lavoura de seus clientes.
Atualmente, a empresa conta com três tipos de bioinsumos feitos a partir do fungo, são eles: TrikoFit para tratamento e proteção da semente contra patógenos de solo (Trichoderma harzianum, cepa IB19/17); Biogreen para pulverização aérea ou aplicação no sulco de plantio em formulação pó molhável (Trichoderma harzianum, cepa IB19/17); e o TrikoSoil, em formulação granulada para dispersão a lanço ou no adubo, contando com quatro cepas de Trichoderma spp. em sua composição (duas linhagens de Trichoderma harzianum, IBLF1228 e IBLF1282 e duas de Trichoderma viride, IBLF1275 e IBLF1276).
Bioinsumos no controle de doenças do solo
Segundo o fitopatologista e Gerente Especialista de Fungos da Solubio, doutor Magno Rodrigues de Carvalho Filho, o conceito de controle de doenças na agricultura mudou nas últimas décadas. Anteriormente, o objetivo era eliminar completamente o patógeno com o uso indiscriminado e contínuo de produtos químicos, sem medir as consequências. Esse procedimento provocou alterações no ambiente, como a seleção de patógenos resistentes, ocorrência de surtos de doenças consideradas secundárias, diminuição de microrganismos benéficos, além dos efeitos nocivos aos seres humanos, animais e na qualidade ambiental, com o crescente acúmulo de resíduos no solo, na água e nos alimentos.
“Nos dias atuais, tem-se notado uma crescente preocupação, em todo o mundo, com os problemas ambientais decorrentes das diversas atividades humanas, incluindo a agricultura. Essa preocupação, que se traduz na busca por uma agricultura ‘limpa’, alimentos sem resíduos e conservação dos recursos naturais, demanda novas tecnologias assentadas nos conceitos ecológicos e de sustentabilidade. O controle biológico se ajusta a esses conceitos, por isso, vem ganhando mais espaço nos últimos anos”, explica o especialista. Dessa forma, é que surgem os bioinsumos criados a partir dos fungos, especialmente o Trichoderma.
Benefícios do Trichoderma para a agricultura
Os biofungicidas são resultados de um processo que inclui a seleção do agente de biocontrole, com extensiva avaliação da eficácia, desenvolvimento do formulado, registro, produção em larga escala e avaliação de mercado, conforme destaca o dr. Magno. Eles podem ser aplicados diretamente no solo ou em tratamento de sementes ou, ainda, pulverizados em partes aéreas, a depender da parte da planta que se deseja proteger.
O sucesso no uso de espécies de Trichoderma spp. no biocontrole de fitopatógenos reside em sua alta capacidade reprodutiva, habilidade de sobreviver em condições desfavoráveis, eficiência na mobilização e absorção de nutrientes (como o fosfato), capacidade de modificar a rizosfera (acidificação pela produção de ácidos orgânicos), agressividade contra fungos fitopatogênicos e eficiência como promotores de desenvolvimento das plantas e na estimulação dos seus mecanismos de defesa.
Além dos efeitos de Trichoderma spp. no controle de patógenos de plantas, ao longo dos estudos realizados pela equipe científica da SoluBio, tem sido observado que certas linhagens de Trichoderma tem a capacidade de se estabelecerem na rizosfera e estimularem diretamente o crescimento vegetal. “Assim, estes fungos vêm se destacando como promotores de crescimento de plantas e no incremento da germinação de sementes. Entre outras vantagens, algumas cepas de Trichoderma tornaram-se resistentes a fungicidas quando expostos a estes; tais linhagens resistentes, quando antagônicas a um patógeno particular, podem ser empregadas juntamente com fungicidas para controle de doenças”, explica o Gerente Especialista de Fungos.
Outra característica relevante na aplicação de Trichoderma no biocontrole de doenças é pelo seu comportamento como endófito, isto é, algumas cepas de Trichoderma spp. tem a capacidade penetrar intercelularmente nas raízes das plantas sem causar doença ou prejuízo agronômico, sugerindo assim que características ligadas à proteção contra fitopatógenos e produção fúngica de hormônios vegetais como o ácido indolacético (AIA) seja uma coevolução desses fungos benéficos com as plantas.
O objetivo da SoluBio, então, ao “inundar” as lavouras com Trichoderma é a redução da densidade de inóculo ou das atividades determinantes da doença provocada por um patógeno ou parasitando seus estados de atividade ou dormência pela introdução em massa dos seus esporos. Esse método “inundativo” utilizando Trichoderma tem sido usado com sucesso no controle de vários fitopatógenos presentes nas grandes culturas de grãos, plumas, hortaliças, frutas e na silvicultura dos clientes da empresa.
Fonte: SoluBio
Por: Portal do Agronegócio